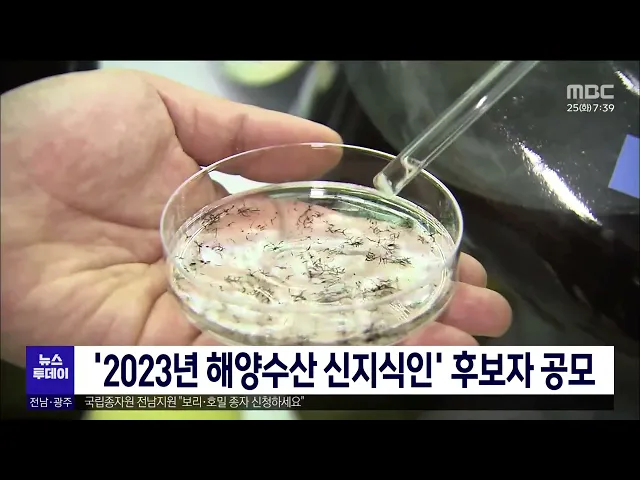

기자별
-
'2023년 해양수산 신지식인' 후보자 공모
전라남도해양수산과학원은 수산업과 어촌 혁신을 주도할 '해양수산 신지식인' 후보자 공모에 나섭니다. 전남해양수산과학원은 유통·가공과 해면양식, 어촌관광 등 7개 분야에서 5명을 선발할 예정이며 신지식인으로 선발되면 수산인력 양성과 어촌발전을 위한 역할을 맡게 됩니다.
최다훈 2023년 07월 25일 -

전남교육청, 교육부 학교복합시설 20곳 선정 목표
전남교육청은 학교와 지역사회에서 필요한 체육관과 도서관 문화시설 등을 교육청과 지자체가 협력해 설치하는 '학교복합시설' 20곳 선정을 목표로 추진합니다. 학교복합시설은 교육부가 오는 2천27년까지 5년간 모두 2백개 학교를 공모를 통해 선정해 1조8천억원을 지원할 예정인데, 현재 전남에서는 완도와 광양 2곳이 ...
신광하 2023년 07월 25일 -

시간당 67mm 폭우에 축사 잠겨 '살려주소~~'(R)
◀ANC▶ 밤사이 전남 곳곳에 폭우가 쏟아졌습니다. 특히 함평에는 시간당 67mm의 많은 비가 내렸는데요 절개지와 축대 붕괴는 물론 축사까지 물에 잠기면서 주민들은 망연자실해야 했습니다. 서일영 기자가 취재했습니다. ◀END▶ ◀VCR▶ 축사 지붕 바로 밑까지 물에 잠겼습니다. 축사 안에 있는 소들은 머리만 내놓고 ...
서일영 2023년 07월 24일 -

만조까지 겹치면서 도심 곳곳 '물바다'(R)
◀ANC▶ 목포에서는 일부 도로가 50년 만에 침수돼 차량 통행이 전면 통제되기도 했습니다. 만조시간까지 겹치면서 침수 피해가 컸습니다. 안준호 기자가 취재했습니다. ◀END▶ ◀VCR▶ 폭우가 쏟아진 오늘 새벽 목포시 석현동 왕복 8차선 도로가 물바다로 변했습니다. 차량들은 물보라를 일으키며 힘겹게 도로를 빠져 ...
안준호 2023년 07월 24일 -

평년 장마 강수량의 2배 쏟아졌다.. 장마는 언제까지?(R)
◀ANC▶ 지난달 25일부터 시작한 올해 장마, 전체 장마기간 평년값의 2배 이상의 강수량을 기록했습니다. 이제 장마가 끝나나했더니 이번엔 태풍 독수리가 북상하고 있어 장마 종료 시점은 아직 예측할 수가 없습니다. 김진선 기자가 보도합니다. ◀END▶ ◀VCR▶ 주말부터 사흘 동안 많은 비가 쏟아진 광주*전남 신안군...
김진선 2023년 07월 24일 -

계속된 장마로 목포종합경기장 완공 8월로 연기
목포종합경기장 공사가 계속된 장마로 완공 시기가 당초 7월 말에서 8월로 연기됐습니다. 목포시는 계속되는 장마로 외부 공사에 어려움이 있다며 8월까지 현재 추진 중인 지붕공사와 트랙공사 등을 마무리해 전국체전을 차질 없이 준비하겠다고 밝혔습니다. 제104회 전국체전은 10월 13일~19일 주개최지인 목포시를 중심으...
최다훈 2023년 07월 24일 -

서영암농협-경희대 연합의료 동아리, 수해 피해 의료봉사
서영암농협은 집중호우로 피해를 입은 조합원들을 위해 경희대학교 연합의료 동아리와 함께 의료봉사에 나섰습니다. 서영암농협과 경희대학교 연합의료 동아리는 이재민 대피소에 대형 선풍기 등 물품을 지원하고 침수로 인한 조합원들의 질병예방과 전염병 차단을 위해 긴급의료봉사를 실시했습니다. 한편 서영암농협의 이...
김양훈 2023년 07월 24일 -

"우리는 한국에서 온 학생들입니다."(R)
◀ANC▶ 전남민주시민토론학교 유럽 탐방 소식입니다. 전남지역 학생들은 독일의 단결과 평화를 상징하는 브란덴부르크 문에서 단심줄 놀이를 펼쳤습니다. 마지막 분단국가인 대한민국의 평화와 화합을 세계인들에게 알리기 위해서 입니다. 박종호 기자가 취재했습니다. ◀END▶ ◀VCR▶ 붉은색과 푸른색 옷을 입은 학생...
박종호 2023년 07월 24일 -

완도 해양수산박물관 타당성 평가 '비상' 문체부 보완 요구
문화체육관광부가 완도에 건립될 예정인 국립해양수산박물관 사전타당성 평가에 대해 보완 요구를 내렸습니다. 전라남도는 아직 해수부로부터 구체적인 보완 사항을 전달받지 못했는데 평가자료를 보완해 오는 9월, 문체부 타당성평가를 재추진한다는 방침인 것으로 알려졌습니다. 한편 국립해양수산박물관 건립사업은 해양...
김양훈 2023년 07월 24일 -

'전남연구원' 공식출범.. 6실·2단·9센터 체제
광주·전남연구원에서 분리된 전남연구원이 독자적 정책연구기관으로 새롭게 출범했습니다. 전남연구원은 조직개편을 통해 '6실·2단·9센터' 체제로 전환했으며 당분간 장헌범 전남도 기획조정실장이 원장 직무대행을 맡고, 전남에 특화된 연구 수요에 대응하기 위해 앞으로 인력 충원을 통해 업무 시스템을 정비해 나가기로 ...
허연주 2023년 07월 24일